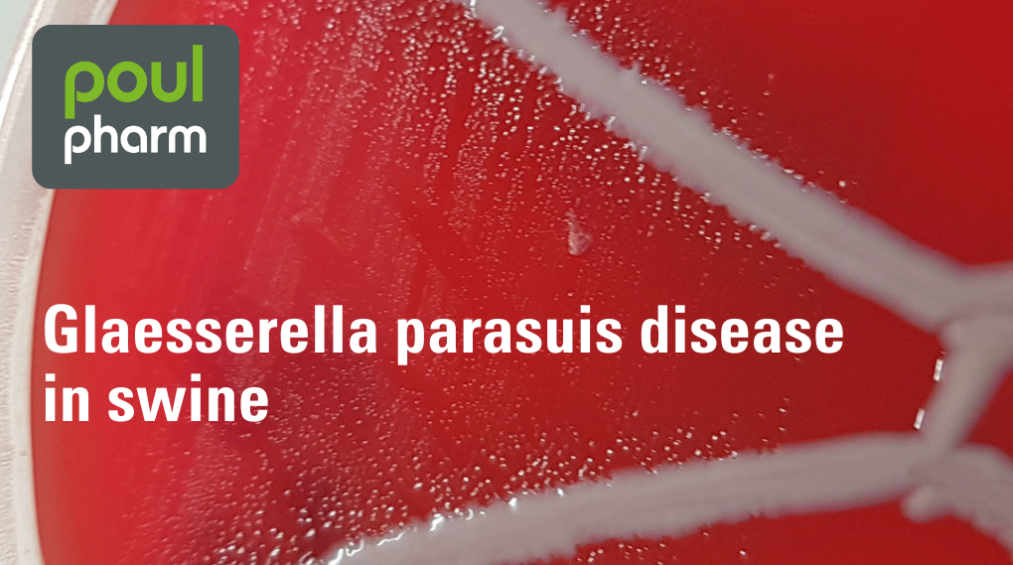

table of contents
Poulpharm Glaesserella parasuis
Glaesserella parasuis has a high genetic variability and can generate complex co-infections. This article describes some practical steps to reduce Glässer’s disease impact.
Glaesserella parasuis has a high genetic variability and can generate complex co-infections. This article describes some practical steps to reduce Glässer’s disease impact.
Glaesserella (Haemophilus) parasuis is responsible for Glässer’s disease and it remains a key pathogen in the swine health landscape, particularly around weaning and other stress-related periods. Although commonly present in the upper respiratory tract, disease arises when virulent strains coincide with stress or co-infections.
Why it still matters?
The diversity challenge
The diagnostic challenge

Main control measures
- Reduce exposure: Optimize ventilation, density, and mixing strategies, batch integrity.
- Target protection timing: Align preventive protection windows with known risk periods.
- Strain-aligned decisions: use local strain information to evaluate the match or mismatch with available protection and adjust accordingly.
- Monitor continuously: Track circulating serotypes/strains and evaluate outcomes to refine prevention strategies.
How Poulpharm can help
Poulpharm supports veterinarians with:
- Diagnostic workflows and sampling guidance
- Strain characterization and sequencing
- Data interpretation and outcome review
Our goal is to help you align preventive strategies with on-farm realities.
If you’d like to discuss sampling plans, optimal timing, or interpretation of recent results, our team will be happy to assist.
Do not hesitate to ask your questions, Poulpharm’s experts team are here to solve your problems!
post tags :
No tags to display. Try to select another taxonomy.
your ideal recruitment agency


